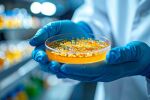
AI може да се превърне в новото оръжие срещу нелечими инфекции

Десетилетия наред онколозите разчитат на микроскопско изследване на биопсии, за да преценят колко опасен е един тумор.
Но този традиционен подход често пропуска фини детайли, които могат да разкрият истинската агресивност на рака. Сега изкуствен интелект обещава да промени начина, по който лекарите решават кои пациенти се нуждаят от химиотерапия, а кои могат безопасно да я избегнат.
Норвежката стартираща компания DoMore Diagnostics разработва AI инструмент, който анализира тъканните проби с далеч по-голяма прецизност от човешкото око и дава по-точни прогнози за развитието на колоректалния рак.
Проблемът с традиционния подход към химиотерапията
Колоректалният рак е третият най-разпространен и вторият най-смъртоносен рак в света, според Световната здравна организация. През 2022 г. само в Европа са регистрирани 2,74 млн. нови случая на рак, сочат данни на Европейската комисия, публикувани в Европейската информационна система за рака (ECIS).
Въпреки че повечето пациенти с колоректален рак се излекуват само с операция, химиотерапията често следва като "универсален подход", дори когато не носи полза на пациента.
„Има огромни подобрения в грижите за раковите пациенти през последните години, но все още много хора получават токсично лечение без никакви ползи", обяснява Торбьорн Фурусет, изпълнителен директор на DoMore Diagnostics.
Според компанията между 96 и 98% от пациентите в стадий II и 80% от тези в стадий III са изложени на краткосрочни и дългосрочни странични ефекти от химиотерапия, без да постигнат подобрени резултати.
Как работи AI инструментът?
Инструментът използва изкуствен интелект, обучен върху хиляди дигитални изображения на ракови тъкани. Системата сканира същите биопсични проби, които патолозите изследват под микроскоп, но идентифицира модели, които човешкото око не може да забележи.
„Когато разработваме AI решенията, ние въвеждаме тези изображения директно, заедно с резултата от състоянието на пациентите няколко години след операцията", разказва Андреас Клепе, директор по изследванията в Университетската болница в Осло. „След това караме компютъра да види връзката между тях. Не разчитаме на оценката на патолога, а само на крайния резултат."
Алгоритъмът предсказва колко бързо ще расте ракът и колко рискован е, като комбинира стотици характеристики на тъканта, които човешкият специалист може да пропусне или да не разпознае като важни.
Какво прави AI технологията по-точна?
Според изследователите инструментът улавя много от характеристиките, които патолозите също търсят, но ги комбинира по начини, които надхвърлят човешките възможности.
„Всъщност не знаем точно какво търси изкуственият интелект", признава Клепе. „Но сме съпостави резултатите с оценките на патолозите и виждаме, че имат смисъл. AI вижда неща, които патолозите може да не знаят."
Тази подобрена точност помага на лекарите да персонализират лечението, да решат кои пациенти наистина се нуждаят от агресивни терапии като химиотерапия и кои могат безопасно да ги избегнат.
Защо прогнозният анализ е толкова важен?
След операция за отстраняване на тумора някои пациенти все още могат да имат малки метастази, вторични ракови огнища, разпространили се от оригиналния тумор.
Точното разбиране какво представлява висок риск от метастази и какво нисък риск е изключително трудно за човек да прецени, защото процесът е много сложен, обяснява Фурусет.
Традиционният подход води до свръхлечение на хиляди пациенти, които биха се излекували и без допълнителна терапия, но в същото време ги излага на:
- Краткосрочни странични ефекти: гадене, умора, загуба на коса, понижен имунитет.
- Дългосрочни усложнения: увреждане на нервната система (невропатия), сърдечни проблеми, повишен риск от вторични ракови заболявания.
Глобално разпространение на технологията
Инструментът е създадена въз основа на научно сътрудничество между Оксфордския университет, Университетската болница в Осло и University College London (UCL).
Понастоящем тестът за колоректален рак на компанията се използва за валидиране на прогностични анализи в болници в Европа, САЩ, Япония и Мексико.
„Ние персонализираме лечението на рака, като използваме силата на изкуствения интелект", подчертава Фурусет. „С AI и големи данни, хиляди образци, сме супер специализирали алгоритъма."
Какво означава това за бъдещето на онкологията?
Развитието на AI технологии в медицината отваря нови възможности за прецизна онкология, подход, при който лечението се адаптира към индивидуалните характеристики на всеки пациент и неговия рак.
Въпреки че инструментът все още да е в процес на внедряване, резултатите са обещаващи. Ако технологията бъде широко приета, хиляди пациенти ежегодно могат да избегнат ненужна химиотерапия и свързаните с нея токсични ефекти, като същевременно получават оптималното лечение според техния индивидуален риск.
Изкуственият интелект вече променя начина, по който лекарите диагностицират и лечат рака. AI инструментът демонстрира как технологията може да надмине човешките възможности в анализа на сложни медицински данни и да помогне за по-точно определяне кои пациенти се нуждаят от химиотерапия.
С навлизането на такива иновации в клиничната практика бъдещето на онкологичното лечение се насочва към персонализиран подход, който максимизира ползите и минимизира рисковете за всеки отделен пациент.
Съдържанието е информативно и не представлява консултация, препоръка или съвет. При въпроси относно вашето здраве, медицинско състояние или лечение, задължително се консултирайте с медицински специалист.
-----------------------------------------
Източници
- Euronews Health - „Този инструмент за изкуствен интелект може да спести на раковите пациенти ненужна химиотерапия“
- European Cancer Information System (ECIS) - Статистика за раковите заболявания в Европа
https://ecis.jrc.ec.europa.eu/ - Световна здравна организация (WHO) - Данни за колоректалния рак в света
- DoMore Diagnostics - Информация за AI технологията за прогностичен анализ на колоректален рак